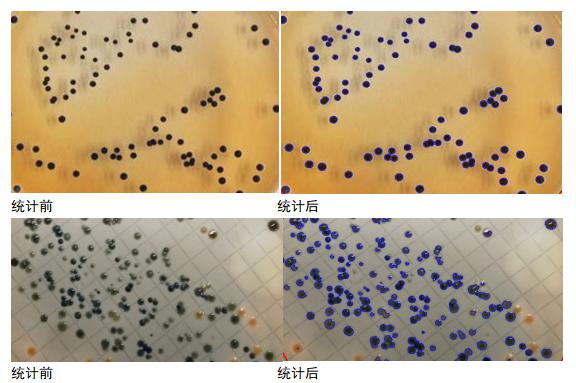

統(tǒng)計(jì)效果:
ColonyAnalyse軟件內(nèi)置多種算法,可以實(shí)現(xiàn)不同顏色的培養(yǎng)基及不同特征的菌落的識(shí)別和復(fù)雜統(tǒng)計(jì),并且設(shè)有靈敏度調(diào)節(jié)按鈕,讓用戶(hù)通過(guò)調(diào)節(jié)靈敏度獲得需要的統(tǒng)計(jì)效果。

統(tǒng)計(jì)區(qū)域:
ColonyAnalyse軟件可以實(shí)現(xiàn)圓形、方形和多邊形統(tǒng)計(jì)區(qū)域選擇功能,用戶(hù)可以通過(guò)選擇不同形狀,統(tǒng)計(jì)需要的平皿區(qū)域。

粘連分割:
ColonyAnalyse軟件具有粘連分割功能,可以通過(guò)手動(dòng)分割粘連的菌落,使統(tǒng)計(jì)結(jié)果更加準(zhǔn)確。

區(qū)域刪除:
ColonyAnalyse軟件具有區(qū)域刪除功能,可以通過(guò)手動(dòng)自由選擇區(qū)域刪除不需要統(tǒng)計(jì)的菌落,獲得需要統(tǒng)計(jì)的部分。

菌落標(biāo)注:
ColonyAnalyse軟件具有菌落標(biāo)準(zhǔn)功能,可以將培養(yǎng)皿中任意位置的菌落進(jìn)行圖片標(biāo)注,把用戶(hù)需要的信息標(biāo)準(zhǔn)在菌落上保存。

數(shù)據(jù)保存:
ColonyAnalyse軟件具有數(shù)據(jù)保存功能,每次處理完畢的菌落圖片,通過(guò)輸入樣本名稱(chēng)、樣本編號(hào)、接種量等信息,可以保存在數(shù)據(jù)庫(kù)中,隨時(shí)可以調(diào)取查看歷史數(shù)據(jù)。

報(bào)告生成:
ColonyAnalyse軟件具有報(bào)告生成功能,通過(guò)數(shù)據(jù)查詢(xún)進(jìn)入數(shù)據(jù)庫(kù),選擇日期或者搜索樣品名稱(chēng)等信息,可以快速查找數(shù)據(jù),同時(shí)手動(dòng)輸入單位名稱(chēng)、項(xiàng)目名稱(chēng)、檢驗(yàn)人、檢驗(yàn)日期、方法名稱(chēng)、標(biāo)準(zhǔn)號(hào)等信息,點(diǎn)擊報(bào)告即可生成PDF格式檢驗(yàn)報(bào)告。











良品鋪?zhàn)?/div>



客服1